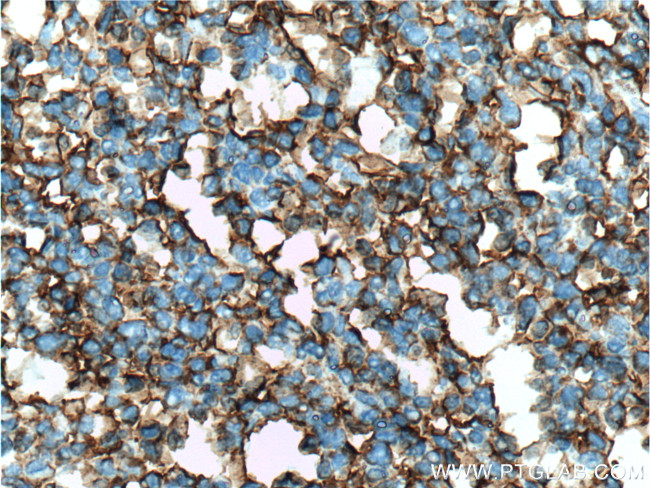
ICAM-1 Antibody in Immunohistochemistry (Paraffin) (IHC (P))

Search
Proteintech
ICAM-1 Monoclonal Antibody (2F9A8)
{{$productOrderCtrl.translations['antibody.pdp.commerceCard.promotion.promotions']}}
{{$productOrderCtrl.translations['antibody.pdp.commerceCard.promotion.viewpromo']}}
{{$productOrderCtrl.translations['antibody.pdp.commerceCard.promotion.promocode']}}: {{promo.promoCode}} {{promo.promoTitle}} {{promo.promoDescription}}. {{$productOrderCtrl.translations['antibody.pdp.commerceCard.promotion.learnmore']}}












Please note: We are reviewing Western blot images included in the antibody testing data in our catalog, including those provided by third parties. Unless expressly labeled or annotated as “raw-unedited”, Western blot images included in the antibody testing data in our catalog may have been edited, optimized or otherwise adjusted for presentation.
产品信息
60299-1-IG
种属反应
已发表种属
宿主/亚型
分类
类型
克隆号
抗原
偶联物
形式
浓度
规格
纯化类型
保存液
内含物
保存条件
运输条件
产品详细信息
Immunogen sequence: GANFSCRTE LDLRPQGLEL FENTSAPYQL QTFVLPATPP QLVSPRVLEV DTQGTVVCSL DGLFPVSEAQ VHLALGDQRL NPTVTYGNDS FSAKASVSVT AEDEGTQRLT CAVILGNQSQ ETLQTVTIYS FPAPNVILTK PEVSEGTEVT VKCEAHPRAK VTLNGVPAQP LGPRAQLLLK ATPEDNGRSF SCSATLEVAG QLIHKNQTRE LRVLYGPRLD ERDCPGNWTW PENSQQTPMC QAWGNPLPEL KCLKDGTFPL PIGESVTVTR DLEGTYLCRA RSTQGEVTRK VTVNVLSPRY EIVIITVVAA AVIMGTAGLS TYLYNRQRKI KKYRLQQAQK GTPMKPNTQA TPP (181-532 aa encoded by BC015969)
靶标信息
ICAM-1 (CD54) is an 85-110 kDa single-chain type 1 integral membrane glycoprotein with an extracellular domain of five immunoglobulin superfamily repeats, a transmembrane region and a cytoplasmic domain. ICAM-1 has 7 potential N-linked glycosylation sites and shares considerable amino acid sequence homology with ICAM-3 (CD50) and ICAM-2 (CD102). ICAM-1 binds to integrins of type CD11a/CD18 (leukocyte adhesion molecule, LFA-1), or CD11b/CD18 (Mac-1) and is exploited by Rhinovirus as a receptor. ICAM-1 is expressed by activated endothelial cells and detected on epithelial cells, fibroblasts, chondrocytes, B lymphocytes, T lymphocytes (low), monocytes, macrophages, dendritic cells and neutrophils, with lower levels that increase upon inflammation. ICAM-1 is also detected in some carcinoma and melanoma cells. Soluble ICAM-1 is detectable in the plasma and is elevated in patients with various inflammatory syndromes.
仅用于科研。不用于诊断过程。未经明确授权不得转售。
生物信息学
蛋白别名: CD54; Human rhinovirus receptor; ICAM-1; Intercellular adhesion molecule 1; Ly 47; Major group rhinovirus receptor; MALA2; sCD54; soluble CD54; Surface antigen of activated B cells
基因别名: ICAM1
Entrez Gene ID: (Human) 3383